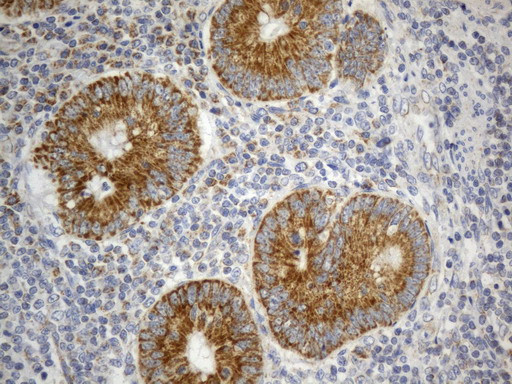
SDHB Antibody in Immunohistochemistry (Paraffin) (IHC (P))

Search
OriGene
SDHB Monoclonal Antibody (UMAB268), UltraMAB™
{{$productOrderCtrl.translations['antibody.pdp.commerceCard.promotion.promotions']}}
{{$productOrderCtrl.translations['antibody.pdp.commerceCard.promotion.viewpromo']}}
{{$productOrderCtrl.translations['antibody.pdp.commerceCard.promotion.promocode']}}: {{promo.promoCode}} {{promo.promoTitle}} {{promo.promoDescription}}. {{$productOrderCtrl.translations['antibody.pdp.commerceCard.promotion.learnmore']}}
产品信息
UM800158
种属反应
宿主/亚型
分类
类型
克隆号
抗原
偶联物
形式
浓度
纯化类型
保存液
内含物
保存条件
运输条件
靶标信息
Complex II of the respiratory chain, which is specifically involved in the oxidation of succinate, carries electrons from FADH to CoQ. The complex is composed of four nuclear-encoded subunits and is localized in the mitochondrial inner membrane. The iron-sulfur subunit is highly conserved and contains three cysteine-rich clusters which may comprise the iron-sulfur centers of the enzyme. Sporadic and familial mutations in this gene result in paragangliomas and pheochromocytoma, and support a link between mitochondrial dysfunction and tumorigenesis.
仅用于科研。不用于诊断过程。未经明确授权不得转售。
篇参考文献 (0)
生物信息学
蛋白别名: FLJ92337; Ip; iron-sulfur subunit; Iron-sulfur subunit of complex II; Malate dehydrogenase [quinone] iron-sulfur subunit; OTTHUMP00000044624; succinate dehydrogenase [ubiquinone] iron-sulfur subunit; Succinate dehydrogenase [ubiquinone] iron-sulfur subunit, mitochondrial; succinate dehydrogenase complex subunit B, iron sulfur (Ip); succinate dehydrogenase complex, subunit B, iron sulfur (Ip)
基因别名: CWS2; IP; PGL4; SDH; SDH1; SDH2; SDHB; SDHIP
UniProt ID: (Human) P21912
Entrez Gene ID: (Human) 6390